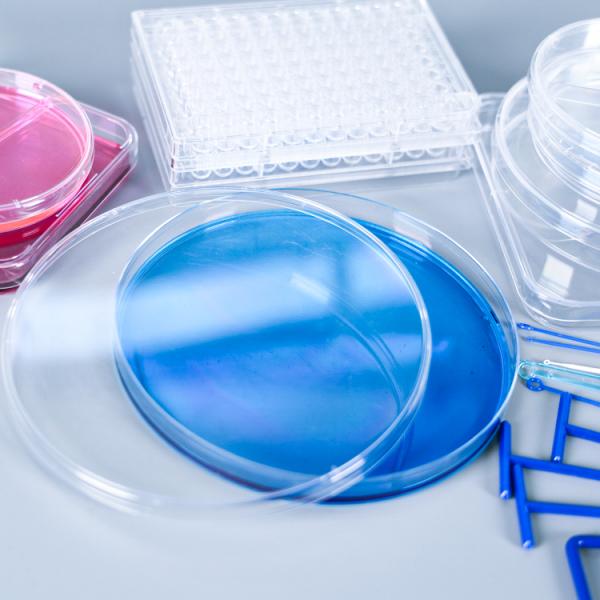
cell culture

| Sign In | Join Free | My benadorassociates.com |
|
| Categories | Plastic Petri Dish |
|---|---|
| Brand Name: | jiang |
| Model Number: | YCD-04 |
| Certification: | CE,ISO |
| Place of Origin: | Jiangsu,china |
| MOQ: | 99+ |
| Payment Terms: | D/P, T/T, L/C, Western Union, L/C |
| Supply Ability: | 1000000 Piece/Pieces per Month |
| Delivery Time: | 7-12days |
| Packaging Details: | 1000pcs/carton |
| Warranty: | 3 years |
| Classification: | Petri Dish |
| Customized support: | OEM, ODM |
| Material: | plastic |
| color: | transparent |
| sample: | free |
| Shape: | round,square |
| Application: | Laboratory Usage |
| Product name: | Petri culture Dishes |
| Company Info. |
| KunShan JiAn Biotech Co., Ltd. |
| View Contact Details |
| Product List |
Plastic Laboratory Sterilized Disposable Sterile Petri Culture Dishes With Lids For Lab Plate Bacterial Yeast
Description
The plastic Petri dishes sold by Ji'an Biology have the characteristics of high transparency, no impurities, good elasticity, and not fragile. They were sterilized by standard concentration gamma rays to ensure sterility. High-quality raw materials are made of imported optically clear virgin polystyrene with excellent workmanship. A variety of specifications, any choice. We can provide various specifications of round Petri dishes, square Petri dishes, and split Petri dishes. A variety of options to meet your experimental needs.
Petri dish is a laboratory vessel used for the cultivation of microorganisms or cells, consisting of a flat disc-shaped base and a lid, usually made of plastic. It is suitable for the inoculation, streaking, and isolation of laboratory bacteria, and can be used for the cultivation of plant materials. Note: If the experiment is over and the Petri dish cannot be used up in time, please pack and seal it in the original packaging bag in time, or place it in a sterile clean room.
Features
- Strict selection of high-quality raw materials.
It is made of high-quality materials, strictly selected materials, and does not cut corners.
- Excellent workmanship.
From the inside out, the quality is supreme, the surface is smooth and free of impurities, the hand feels delicate, and it is not easy to damage.
- compact structure.
Thickened material, solid material, compact structure, not easy to deform and break.
- Support customization.
A large number of regular stock, accept drawings, processing, and customization.
Specification
Cell Culture Products Catalogue-Yong Yue.pdf
| Name | Specs | Number | QTY | DIM |
Round Culture Dishes | 35*15mm | YCD-01 | 10 pcs/bag, 2000 pcs/carton | 42*42*27cm |
| 60*15mm | YCD-02 | 10 pcs/bag, 1000 pcs/carton | 63*33*32cm | |
| 70*15mm | YCD-03 | 10 pcs/bag, 1000 pcs/carton | 74*38*35cm | |
| 90*15mm | YCD-04 | 10 pcs/bag, 500 pcs/carton | 48*48*32cm | |
| Automation 90*15mm | YCD-09 | 10 pcs/bag, 500 pcs/carton | 48*48*32cm | |
| 90*20mm | YCD-05 | 10 pcs/bag, 500 pcs/carton | 48*48*43cm | |
| 100*15mm | YCD-10 | 10 pcs/bag, 500 pcs/carton | 53*53*32cm | |
| 120*15mm | YCD-11 | 10 pcs/pack, 320 pcs/carton | 49*49*44cm | |
| 150*15mm | YCD-12 | 10 pcs/bag, 200 pcs/carton | 77*32*35cm |
| Name | Specs | Number | QTY | DIM |
Round Culture Dishes | 2rooms 90*15mm | YCD-06 | 10 pcs/bag, 500 pcs/carton | 48*48*32cm |
| 3rooms 90*15mm | YCD-08 | 10 pcs/bag, 500 pcs/carton | 48*48*32cm | |
| 4rooms 90*15mm | YCD-07 | 10 pcs/bag, 500 pcs/carton | 48*48*32cm |
| Name | Specs | Number | QTY | DIM |
Square Culture Dishes | 100*100mm with Non Scale | YCD-13-NS | 10 pcs/pack, 500 pcs/carton | 56*56*37cm |
100*100mm with Scale | YCD-13-S | 10 pcs/pack, 500 pcs/carton | 56*56*37cm | |
| 130*130mm | YCD-14 | 10 pcs/bag, 300 pcs/carton | 67*41*35cm |
More pictures
Why choose us?
JiAn Biotech Co., Ltd. is a factory and one of the leading high-quality medical and laboratory products manufacturers and suppliers in China since 2001. Our main products include Petri dishes, test tubes, cuvettes, sample cups, urine containers, and other related medical lab plastic consumable products. Our main market: Southeast Asia, ASEAN, US, European Union, Russia, Japan, etc.Welcome to visit our company for further cooperation.
|